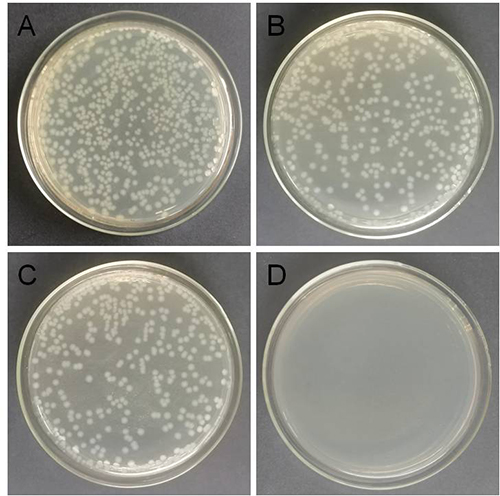

最近,沈阳材料科学国家研究中心刘洪阳研究员和博士研究生孟凡池等人与北京大学马丁教授、辽宁大学夏立新教授、香港科技大学王宁教授、中科院上海应用物理所姜政研究员以及中科院山西煤化所温晓东研究员等团队合作,通过对亚纳米尺度Cu金属团簇结构的精准调控,成功构建亚纳米尺度下原子级分散且全暴露Cu3团簇纳米酶,并表现出优异的模拟氧化酶活性与抗菌性能。近日,《应用催化B:环境》(Applied Catalysis B: Environmental) 在线发表了该项研究成果(DOI:10.1016/j.apcatb.2021.120826)。
随着现代社会的不断进步与发展,越来越多的病菌也随之出现,并严重的威胁着人类的健康。大量抗生素和药物的广泛使用使一些病菌产生了耐药性,所以寻找新型抗菌材料刻不容缓。氧化应激作用是灭杀细菌的一种有效方法,通过活性氧物质作用于细菌,破坏细菌细胞内部的新陈代谢,导致细菌失活。纳米酶是一类具有模拟酶催化活性的纳米材料,其因强大多样的酶催化活性而备受关注。研究发现一些纳米酶具有模拟氧化酶、过氧化物酶等催化活性,其产生的活性氧物质可以有效的灭活细菌。目前,在构建具有优异模拟酶催化活性的新型纳米酶方面仍然存在挑战。近年来,单原子金属纳米酶的发现引起了人们的极大关注。原子级分散的金属活性位点最大化实现金属原子的利用率,且可以精确设计和控制孤立金属原子的配位结构,这有助于理解纳米酶的结构-性能关系。然而,由于在一些反应中缺少邻近位点,单原子金属催化剂可能会遇到催化效率低和催化剂烧结等问题。与单原子催化剂相比,亚纳米尺度原子级分散且完全暴露的金属团簇催化剂不仅能提供相邻的金属原子作为催化位点,而且能保持充分的原子利用效率,提供了多种结构可能性和催化可行性。将这种原子级分散且完全暴露的金属团簇催化剂应用于抗菌领域,可以有效的提升抗菌性能保护人们的健康。
刘洪阳研究员团队近年来一直致力于亚纳米尺度金属催化材料的设计与应用研究。在前期研究工作基础之上,研究团队在纳米金刚石-石墨烯杂化载体上构造了亚纳米尺度完全暴露Cu金属团簇,经球差电镜(图1)分析表明,原子级分散且完全暴露的Cu3团簇(Cu3/ND@G)锚定在富缺陷石墨烯表面。密度泛函理论(DFT)计算结果表明(图2),亚纳米尺度原子级分散且完全暴露的Cu3团簇作为活性中心有利于O2的吸附,从而促进催化O-O键断裂形成活性氧物质(•OH),显著提高了Cu3/ND@G纳米酶的模拟氧化酶样活性。与Cu单原子纳米酶(Cu1/ND@G)和Cu纳米颗粒纳米酶(Cu-NPs/ND@G)相比,亚纳米尺度完全暴露且原子级分散的Cu3金属团簇纳米酶表现出优异的模拟氧化酶活性(Kcat=1.474×10-1 s-1)。这种完全暴露且原子级分散的Cu3金属团簇纳米酶在NaAc缓冲液(pH4.5)中具有≥99%的抗菌率(图3),其结构和优异的抗菌性能(图4)显示了其在生物医学、微生物防腐等领域的潜在应用价值。
上述工作得到了国家重点研发计划纳米专项青年科学家项目、国家基金委企业创新发展联合基金重点项目、国家基金委碳基能源重大研究计划重点项目、国家基金委国际合作中港联合基金项目、国家基金委面上项目、辽宁省兴英才计划、沈阳材料科学国家研究中心青年人才项目与企业合作项目提供的支持,以及上海同步辐射光源的大力支持。

图1. (A),(B) Cu纳米粒子(Cu-NPs/ND@G) 的球差电镜表征;©,(D) 亚纳米尺度Cu3金属团簇(Cu3/ND@G)的球差电镜表征。

图2. Cu3/ND@G各种中间体沿模拟氧化酶反应路径的优化吸附构型和Cu3/ND@G、Cu-NPs/ND@G模拟氧化酶机理的自由能图。灰色、棕色、红色和白色的球分别代表C、Cu、O和H原子。
图3. 生长抑制试验:将不同的材料和大肠杆菌菌液孵育后涂在LB琼脂平板上。用(A)空白、(B) ND@G、© Cu-NPs/ND@G和(D) Cu3/ND@G处理。培养条件:37℃和24小时。

图4. 亚纳米尺度下Cu3金属团簇活性中心结构与抗菌性能示意图